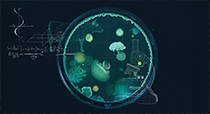

Somos una compañía tecnológica que opera a nivel global aportando soluciones y productos innovadores en sectores de alta exigencia. Nuestros sectores de actividad son Aeroespacio, Defensa, Industria de la ciencia, Biotecnología y Fintech. SECTORES
Industria de la ciencia
Biotecnología
Fintech
CAPACIDADES
Fabricación
Inspecciones, test y ensayos
CONTACTO Grupo Arquimea, S.A. |

C/ Verano, N.º 9, Polígono Industrial Las Monjas
www.arquimea.com/es/28850 Torrejón de Ardoz - Madrid - España
Tel. (+34) 916 89 80 94
politicas@arquimea.com